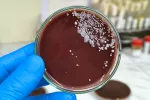

Italfarmaco recibe la aprobación de la FDA para exportar sus medicamentos

16/01/2024
La FDA es la agencia del Departamento de Salud y Servicios Humanos de Estados Unidos que se encarga de certificar la seguridad, eficacia, calidad y protección de los medicamentos, vacunas y otros productos biológicos y dispositivos médicos para uso humano y veterinario. Ahora, la planta de producción de Grupo Italfarmaco, situada en Alcobendas (Madrid), ha recibido la aprobación de este organismo tras pasar unos estrictos controles de calidad.
Esta aprobación constituye un hito histórico para esta compañía farmacéutica, ya que implica el reconocimiento a la calidad de esta planta y a la dedicación y el compromiso de las personas que trabajan en ella. Como explica Álvaro Acebrón, director general de Grupo Italfarmaco en España “ahora nos enfrentamos a un nuevo desafío: mantener este exigente estándar a lo largo de los años. La aprobación de la FDA es solo el comienzo de una nueva fase en la que debemos demostrar constantemente nuestro compromiso con la excelencia y la calidad. Este éxito no solo es un reconocimiento, sino también una gran responsabilidad”.
70% de la producción destinada a la exportación internacional
Las instalaciones del Grupo en Alcobendas disponen de dos plantas de producción diferenciadas, una para líquidos y sólidos orales y otra planta de semi sólidos, que están sometidas a los más estrictos controles de calidad. La compañía cuenta, además, con un equipo dedicado a la I+D formado por más de 40 profesionales que trabajan en el desarrollo de tecnología, proyectos y ensayos clínicos en colaboración con hospitales y centros de investigación de toda España.
Con una extensión de 4.000 m2, tiene un volumen de producción de 3.500 toneladas de más de 55 productos diferentes, entre los que se encuentra la producción de más de 20 millones de unidades de producto terminado en distintas formas farmacéuticas.
La planta de Italfarmaco tiene un volumen de producción de 3.500 toneladas de más de 55 productos diferentes
José Alemán, director de Operaciones Industriales de Grupo Italfarmaco España destaca que “esta aprobación de la FDA es el resultado del arduo trabajo y dedicación de toda la organización. Es un logro que refleja nuestra búsqueda constante de la excelencia y la mejora continua. Estamos comprometidos y obligados a brindar productos farmacéuticos de la más alta calidad para satisfacer las necesidades de los pacientes en el mercado norteamericano”.
El 70% de la producción de la planta de Madrid está destinada a la exportación internacional, para los más de 35 países con los que la compañía trabaja en todo el mundo, como Francia, Alemania, Suecia, Portugal, China, Turquía, Marruecos, Argelia, Vietnam, Méjico o Perú, entre otros, y a los que ahora se suma Estados Unidos.
Actualizado: 16 de enero de 2024